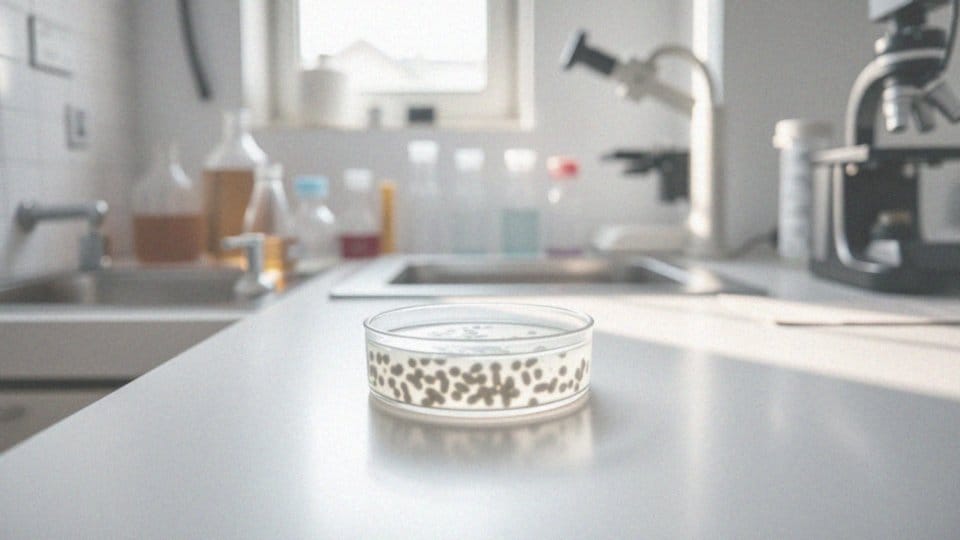

Spis treści
Jakie są podstawowe informacje o badaniu wody ze studni głębinowej?
Badanie wody z głębinowej studni jest niezwykle istotne dla zapewnienia jej bezpieczeństwa i jakości. W przeciwieństwie do wody dostarczanej przez miejskie sieci wodociągowe, woda z własnego ujęcia nie podlega regularnym kontrolom, co sprawia, że to właśnie właściciel studni jest odpowiedzialny za jej jakość. Systematyczne testowanie pozwala na wykrycie ewentualnych zanieczyszczeń, które mogą stanowić zagrożenie dla zdrowia ludzi.
W trakcie analizy badane są różne parametry fizykochemiczne, takie jak:
- pH,
- twardość,
- obecność metali ciężkich,
- substancji organicznych.
Dodatkowo, sprawdza się mikroorganizmy, na przykład bakterie i wirusy, które mogą być niebezpieczne dla zdrowia. Regularne testy umożliwiają weryfikację, czy woda spełnia normy jakościowe i jest bezpieczna do spożycia. Zaleca się przeprowadzanie badań wody niezależnie od tego, jak czysta zdaje się ona na pierwszy rzut oka. Zanieczyszczenia mogą być ukryte i stanowić niebezpieczeństwo dla zdrowia.
Warto zaznaczyć, że koszty związane z badaniami są zwykle niskie w porównaniu do potencjalnych problemów zdrowotnych, jakie mogą wyniknąć z picia zanieczyszczonej wody. Regularne testowanie wody to nie tylko kwestia zdrowia, ale również dbałość o higieniczne normy sanitarno-epidemiologiczne. Właściciele studni powinni być świadomi zalet wynikających z systematycznego monitorowania jakości swojej wody oraz wiedzieć, jak reagować w przypadku wykrycia jakichkolwiek zanieczyszczeń.
Dlaczego warto zlecić badanie jakości wody ze studni?
Zlecenie badania jakości wody ze studni ma kluczowe znaczenie dla zdrowia jej użytkowników oraz standardów spożywanej wody. Dzięki tym analizom można wykryć szkodliwe zanieczyszczenia, w tym:
- bakterie,
- metale ciężkie,
- różnorodne substancje chemiczne.
Regularne monitorowanie wody drastycznie zmniejsza ryzyko spożycia nieodpowiedniej wody, co może prowadzić do wielu problemów zdrowotnych. Systematyczne badania pozwalają na błyskawiczne zidentyfikowanie potencjalnych zagrożeń oraz na wdrożenie skutecznych metod dezynfekcji. W przypadku wykrycia anomalii w wynikach testów, właściciele studni mają szansę na podjęcie działań, takich jak:
- instalacja systemów uzdatniania,
- co znacząco poprawia jakość wody.
Należy pamiętać, że wiele zanieczyszczeń może być niewidocznych gołym okiem, dlatego systematyczne testowanie wody jest konieczne, aby spełniać wymogi sanitarno-epidemiologiczne. Właściciele studni powinni postrzegać badania jakości wody jako inwestycję w zdrowie swoje oraz bliskich, nie zaś jako zbędny wydatek. Zdobycie dokładnych wyników tych badań to fundamentalny krok w dążeniu do zapewnienia, że woda, którą pijemy na co dzień, jest całkowicie bezpieczna.
Gdzie można wykonać badanie wody ze studni głębinowej?

Badanie wody z głębinowej studni powinno być przeprowadzane w akredytowanych laboratoriach, które dysponują odpowiednimi certyfikatami. W Polsce istnieją różne placówki, w tym stacje sanitarno-epidemiologiczne, które oferują tego rodzaju analizy. Przy wyborze laboratorium warto zwrócić uwagę na jego:
- uprawnienia,
- metody, które stosuje.
Możesz zlecić badania zarówno fizykochemiczne, jak i mikrobiologiczne, aby uzyskać pełny obraz jakości wody. Ceny takich analiz mogą się różnić w zależności od zakresu testów. Standardowe badania, obejmujące podstawowe parametry, oferowane są w cenie od 100 do 300 zł. Złożone analizy, które sprawdzają obecność zanieczyszczeń organicznych czy metali ciężkich, mogą wiązać się z wyższymi kosztami.
Takie testy są istotne w szybkim identyfikowaniu potencjalnych zagrożeń dla zdrowia, co pozwala na podjęcie odpowiednich kroków w celu ich neutralizacji. Nie zapomnij również zapoznać się z opiniami oraz doświadczeniem laboratorium w zakresie badań wody ze studni głębinowych. To pomoże ci upewnić się o wysokiej jakości świadczonych usług.
Jak przebiega pobór próbek wody z studni głębinowej?

Pobieranie próbek wody z głębinowej studni to kluczowy element oceny jej jakości. Aby uzyskać wiarygodne i reprezentatywne wyniki, cały proces powinien przebiegać zgodnie z obowiązującymi normami.
Na początku należy odpompować wodę, co pozwala usunąć tę zgromadzoną w rurach i przygotować się do pobrania właściwej próbki. Woda jest następnie przelewana do sterylnych pojemników, co znacznie minimalizuje ryzyko jej zanieczyszczenia.
Tego typu procedury powinny być wykonywane przez wykwalifikowanych specjalistów, którzy dbają o przestrzeganie norm i sporządzają niezbędną dokumentację transportu do laboratorium. Logistyka związana z przewozem próbek również wymaga staranności, ponieważ odpowiednia organizacja jest kluczowa dla ich stabilności oraz zachowania niezmienności.
Oznacza to nie tylko utrzymanie wskazanej temperatury, ale także unikanie warunków, które mogłyby wpłynąć na rezultaty analiz. Badania wody nie tylko ujawniają ewentualne zanieczyszczenia, ale także umożliwiają ocenę zgodności z określonymi standardami jakościowymi.
Program badań obejmuje szczegółową analizę:
- chemiczną,
- mikrobiologiczną,
- fizykochemiczną.
Co więcej, regularne pobieranie próbek stanowi fundament bezpieczeństwa dla użytkowników wody z takich źródeł.
Jakie są regulacje dotyczące badania wody ze studni?
Regulacje dotyczące badań wody ze studni głębinowych są określone w Rozporządzeniu Ministra Zdrowia. Właściciele tych ujęć mają obowiązek systematycznego monitorowania jakości wody, co jest niezwykle istotne dla jej bezpieczeństwa zdrowotnego. Badania powinny uwzględniać zarówno parametry fizykochemiczne, jak i mikrobiologiczne, a kluczowe aspekty to:
- pH,
- twardość,
- obecność metali ciężkich,
- bakterii.
Z zaleceniem przeprowadzania takich analiz przynajmniej raz na rok powinno się reagować na wszelkie zmiany w jakości wody, co może wymagać częstszych badań. Warto pamiętać, że testy powinny być realizowane w akredytowanych laboratoriach, co gwarantuje rzetelność wyników oraz zgodność z obowiązującymi normami sanitarno-epidemiologicznymi. Istotne jest, aby właściciele studni zdawali sobie sprawę, że woda niezbadana może stanowić poważne zagrożenie dla zdrowia. Dlatego przestrzeganie tych regulacji jest tak ważne. Regularne analizy pozwalają na szybkie wykrywanie ewentualnych zanieczyszczeń oraz podejmowanie odpowiednich działań, takich jak instalacja systemów uzdatniania wody.
Co obejmuje analiza wody ze studni głębinowej?
Analiza wody ze studni głębinowej obejmuje dwa główne typy badań: fizykochemiczne oraz mikrobiologiczne. W przypadku badań fizykochemicznych sprawdzane są takie parametry jak:
- pH,
- twardość,
- stężenie metali, w tym żelaza i manganu,
- poziom azotanów i azotynów.
Natomiast w badaniach mikrobiologicznych skupiamy się na identyfikacji bakterii, w tym tych z grupy Coli, takich jak Escherichia coli czy enterokoki, których obecność może świadczyć o zanieczyszczeniu wody odpadami, co stanowi poważne ryzyko zdrowotne. Regularne testy wody są niezbędne dla utrzymania wysokiej jakości i pozwalają na wczesne wykrywanie potencjalnych zagrożeń. Oprócz tego, analiza może obejmować także badania dotyczące substancji organicznych oraz chemicznych zanieczyszczeń.
Dla właścicieli studni kluczowe jest zrozumienie znaczenia tych badań, ponieważ umożliwiają one odpowiednią dbałość o jakość wody wykorzystywanej w codziennym życiu.
Jakie metody badawcze są stosowane w laboratoriach do analizy wody?
W laboratoriach prowadzone są różnorodne analizy wody, które odgrywają kluczową rolę w uzyskiwaniu precyzyjnych wyników. Możemy je podzielić na dwie główne kategorie:
- metody fizykochemiczne: w skład tej grupy wchodzą:
- miareczkowanie, które pozwala ustalić stężenie różnych substancji chemicznych,
- spektrofotometria, oceniająca, w jaki sposób próbki absorbują światło,
- chromatografia, wykorzystywana do rozdzielania oraz analizy składników chemicznych obecnych w wodzie.
- metody mikrobiologiczne: laboratoria wykorzystują techniki hodowlane, które są pomocne w identyfikacji mikroorganizmów w wodzie.
Skupiają się one na wykrywaniu niebezpiecznych bakterii, takich jak Escherichia coli i enterokoki, które mogą stanowić zagrożenie dla zdrowia. Akredytowane procedury badawcze gwarantują wiarygodność wyników i ich zgodność z wymaganiami sanitarnymi. Analiza wody pochodzącej ze studni głębinowych wymaga zastosowania standardowych protokołów, aby uniknąć możliwych błędów. Regulacje dotyczące ochrony środowiska oraz zdrowia publicznego nakładają obowiązek regularnego monitorowania jakości wody. Tego rodzaju badania są niezbędne dla zapewnienia zdrowia i bezpieczeństwa użytkowników.
Jakie parametry fizykochemiczne badane w wodzie?
Analiza fizykochemiczna wody skupia się na istotnych parametrach, które mają kluczowe znaczenie dla jej jakości. Do najważniejszych z nich należą:
- pH: wskazuje na poziom kwasowości lub zasadowości. Wartości poniżej 7 sugerują, że woda jest kwaśna, podczas gdy wyższe niż 7 oznaczają, że jest zasadowa,
- Twardość wody: mierzona w stopniach niemieckich (°dH), informuje o ilości soli wapnia i magnezu, co wpływa na smak oraz zdolności myjące,
- Stężenie żelaza: zwiększone stężenie może powodować nieprzyjemny posmak oraz zabarwienie wody,
- Mangan: prowadzi do osadów,
- Azotany i azotyny: mogą świadczyć o zanieczyszczeniach pochodzących z nawozów sztucznych lub ścieków,
- Przewodność elektrolityczna: ocenia, jak dobrze woda przewodzi prąd elektryczny, co jest powiązane ze stężeniem rozpuszczonych jonów.
Zgromadzenie wszystkich tych informacji pozwala na rzetelną ocenę jakości wody pitnej, jej bezpieczeństwa oraz na wykrycie potencjalnych zagrożeń zdrowotnych. Regularne badania fizykochemiczne, zalecane co najmniej raz w roku, dostarczają nieocenionych danych o stanie wody.
Jakie mikroorganizmy są kontrolowane w badaniach wody?
Mikroorganizmy wskaźnikowe, takie jak bakterie z grupy coli, zwłaszcza Escherichia coli oraz enterokoki, pełnią istotną funkcję w analizie jakości wody z głębinowych studni. Ich obecność sygnalizuje możliwość zanieczyszczenia fekalnego, co stwarza poważne zagrożenie dla zdrowia ludzi. Równocześnie istnieje potrzeba badania innych patogenów, takich jak Clostridium perfringens, które również mogą negatywnie wpływać na nasze zdrowie.
Kluczowe jest przeprowadzanie analizy mikrobiologicznej, aby ocenić stopień zanieczyszczenia wody. To pozwala na szybką identyfikację problemów i podjęcie skutecznych działań ochronnych. W przypadku niepokojących wyników, na przykład wykrycia Escherichia coli, konieczne są natychmiastowe kroki, takie jak:
- dezynfekcja źródła,
- monitorowanie jakości wody,
- prowadzenie regularnych badań mikrobiologicznych.
Takie interwencje przyczyniają się do zminimalizowania ryzyka infekcji. Regularne badania mikrobiologiczne są niezbędne dla zapewnienia bezpieczeństwa wody pitnej, co ma szczególne znaczenie w regionach, gdzie dostęp do wody wysokiej jakości jest ograniczony.
Jakie zanieczyszczenia mogą znajdować się w wodzie ze studni?
Woda z głębinowych studni może być zanieczyszczona różnorodnymi substancjami, zarówno tymi pochodzącymi z natury, jak i wynikającymi z działalności człowieka. Wśród najczęściej występujących zanieczyszczeń znajdują się:
- żelazo,
- mangan,
- azotany,
- azotyny,
- metale ciężkie, takie jak ołów i kadm,
- niebezpieczne mikroorganizmy, na przykład bakterie coli, w tym Escherichia coli oraz enterokoki.
Żelazo i mangan mogą wpływać na zapach oraz smak, a także na kolor wody. Obecność azotanów i azotynów zazwyczaj pochodzi ze stosowania nawozów sztucznych oraz zanieczyszczeń związanych z ściekami, co stwarza ryzyko dla zdrowia, szczególnie u małych dzieci. Warto także zauważyć, że w rolnictwie, gdzie na porządku dziennym są pestycydy, jakość wody również może ucierpieć.
Niebezpieczeństwo stwarzają również metale ciężkie, takie jak ołów i kadm, które mogą dostawać się do wód gruntowych w wyniku niewłaściwego składowania odpadów. Niestety, istnieje także ryzyko obecności niebezpiecznych mikroorganizmów, które świadczą o potencjalnym zanieczyszczeniu fekalnym, co może prowadzić do poważnych problemów zdrowotnych, takich jak infekcje.
Z tego powodu regularne badanie wody jest niezwykle istotne, ponieważ pozwala na wczesne wykrycie zanieczyszczeń i podjęcie odpowiednich kroków w celu zapewnienia bezpieczeństwa osób korzystających ze studni głębinowych. Zaniedbanie tych spraw może prowadzić do poważnych konsekwencji zdrowotnych, dlatego monitoring jakości wody to kluczowy element w dbałości o zdrowie.
Jakie są wyniki badania wody i co pokazują?
Wyniki analiz wody pobranej z studni głębinowej odgrywają kluczową rolę w ocenie jej jakości i bezpieczeństwa użytkowania. Podczas badań sprawdzane są różnorodne parametry fizykochemiczne oraz mikrobiologiczne, a wyniki porównuje się do obowiązujących norm. Jeżeli wykryte zostaną przekroczenia standardów czystości dla jakiegoś z tych parametrów, może to sugerować obecność zanieczyszczeń w wodzie, co z kolei stwarza zagrożenie dla zdrowia osób ją spożywających.
Szczególną uwagę zwraca się na obecność substancji takich jak:
- metale ciężkie,
- azotany,
- azotyny,
- mikroorganizmy, w tym bakterie z grupy coli.
Na przykład, wykrycie Escherichia coli w próbce sygnalizuje zanieczyszczenie fekalne, co wymaga natychmiastowego działania, takiego jak dezynfekcja wody oraz zwiększenie częstotliwości jej monitorowania. W wyniku badań można również zidentyfikować źródła zanieczyszczeń, co pozwala na skuteczną reakcję i wdrożenie odpowiednich działań naprawczych, na przykład poprzez instalację efektywnych systemów uzdatniania wody.
Regularne badania są nie tylko niezbędne do określenia stopnia skażenia, ale również dostarczają cennych wskazówek dotyczących poprawy jakości wody. Systematyczne przeprowadzanie tych analiz jest absolutnie kluczowe, ponieważ wiele zanieczyszczeń pozostaje niewidocznych gołym okiem, a ich obecność może prowadzić do poważnych problemów zdrowotnych.
Jakie działania podjąć po otrzymaniu wyników badania wody?
Otrzymując wyniki badań wody ze studni głębinowej, kluczowe jest ich staranne przeanalizowanie pod kątem norm jakościowych. W sytuacjach, gdy wyniki wykazują nieprawidłowości, bardzo istotne jest szybkie zidentyfikowanie źródła zanieczyszczeń. Często oznacza to konieczność zasięgnięcia rady specjalistów.
W przypadku obecności szkodliwych mikroorganizmów, takich jak Escherichia coli, dezynfekcja wody staje się niezbędna. Można zastosować takie metody jak:
- chlorowanie,
- promieniowanie UV.
Jeżeli zanieczyszczenia mają podłoże chemiczne, warto rozważyć montaż filtrów lub systemów uzdatniania, aby skutecznie usunąć niepożądane substancje. Jeśli jakość wody z prywatnej studni utrzymuje się na niskim poziomie przez dłuższy czas, dobrze jest pomyśleć o poszukiwaniach nowego, bardziej ekologicznego źródła wody pitnej.
Regularne monitorowanie jakości po przeprowadzonych działaniach naprawczych jest kluczowe, aby potwierdzić skuteczność zastosowanych rozwiązań. Warto także pamiętać, że koszty związane z naprawą jakości wody zazwyczaj są znacznie mniejsze niż wydatki na leczenie wynikające z picia zanieczyszczonej wody.
Jakie są najczęstsze zagrożenia związane z wodą pitną ze studni głębinowych?
Woda pitna pochodząca z głębinowych studni może być narażona na różnorodne zagrożenia, które stają się istotnym ryzykiem dla zdrowia. Do najczęściej występujących zanieczyszczeń należą:
- Zanieczyszczenia mikrobiologiczne: obecność bakterii, takich jak Escherichia coli, może sugerować zanieczyszczenie fekalne. Te patogeny niosą ze sobą ryzyko poważnych chorób, w tym infekcji pokarmowych czy biegunek,
- Zanieczyszczenia chemiczne: azotany i azotyny można znaleźć w wodzie w wyniku użycia nawozów sztucznych oraz niewłaściwego zarządzania odpadami. Ich wysokie stężenie stanowi szczególne zagrożenie dla dzieci, gdyż może prowadzić do methemoglobinemii,
- Metale ciężkie: woda może zawierać szkodliwe metale, takie jak ołów czy kadm, które dostają się tam przez korozję instalacji bądź zanieczyszczenia przemysłowe. Nawet niewielkie ilości tych substancji mogą wywołać poważne problemy zdrowotne, w tym uszkodzenia nerek oraz wątroby,
- Zanieczyszczenia fizyczne: zmiany w przejrzystości, mętność, nieprzyjemny zapach lub zmiana koloru mogą wskazywać na obecność różnych ciał obcych, zarówno organicznych, jak i nieorganicznych. Tego typu zanieczyszczenia mogą znacząco wpłynąć na jakość oraz smak wody.
W związku z tym regularne kontrole jakości wody z studni głębinowych są niezbędne do ochrony zdrowia użytkowników. Właściciele studni powinni być świadomi, że zanieczyszczenia mogą występować w ukrytej formie, dlatego systematyczne monitorowanie wody nie tylko zapobiega problemom zdrowotnym, ale również gwarantuje bezpieczeństwo jej spożycia.
Jak monitorować jakość wody ze studni głębinowej?
Monitorowanie jakości wody ze studni głębinowej to kluczowy proces, który wymaga regularnych działań. Ważne jest, aby systematycznie analizować wodę i prowadzić szczegółową dokumentację zarówno studni, jak i jej otoczenia. Niezwykle istotne są również regularne przeglądy i konserwacja sprzętu.
Częstotliwość badań powinna być uzależniona od lokalnych warunków hydrogeologicznych oraz specyfiki danej studni. Zaleca się, aby szczegółowe analizy były przeprowadzane przynajmniej raz w roku. Rozpoczęcie monitorowania jakości wody najlepiej zacząć od ustalenia, jakie parametry będą badane. Wśród nich powinny znaleźć się:
- pH,
- twardość,
- obecność metali ciężkich,
- stężenie azotanów,
- mikroorganizmy, w tym bakterie coli.
Właściciele studni powinni mieć świadomość, że nawet niewielkie odchylenia od norm mogą wskazywać na potencjalne zagrożenia, które wymagają szybkiej interwencji. Dokumentacja dotycząca monitorowania jakości wody pozwala na obserwację zmian w czasie, co z kolei sprzyja szybszemu reagowaniu na różnorodne zagrożenia. Rekomenduje się także współpracę z akredytowanymi laboratoriami, które przeprowadzą dokładne analizy.
Regularne testowanie wody zwiększa bezpieczeństwo jej użytkowników oraz umożliwia wczesne wykrywanie ewentualnych zanieczyszczeń, co ma kluczowe znaczenie dla zdrowia. Warto więc traktować monitoring jakości wody ze studni głębinowej jako proaktywną praktykę, która zapewnia wysoką jakość wody pitnej. Właściciele studni powinni wprowadzić te działania jako standard, aby móc cieszyć się czystą i zdrową wodą.
Jakie są koszty badania wody ze studni głębinowej?
Koszty związane z badaniami wody ze studni głębinowej są zróżnicowane, co wynika z rodzaju analiz oraz laboratorium, które wykonuje te usługi. Zasadniczo badania fizykochemiczne są tańsze w porównaniu do analiz mikrobiologicznych. Ceny standardowego zestawu analiz waha się w przedziale od 100 do 300 zł, a w jego skład wchodzą istotne parametry, takie jak:
- pH,
- twardość wody,
- zawartość metali ciężkich.
Gdy zleca się bardziej skomplikowane analizy, na przykład testy na obecność związków organicznych, koszty niestety rosną. Laboratoria posiadające odpowiednie akredytacje zapewniają rzetelne wyniki zgodne z obowiązującymi normami. Regularne badanie wody w studniach głębinowych to mądra decyzja, mimo ponoszonych wydatków, ponieważ może to zapobiec znacznie wyższym kosztom leczenia związanym z piciem zanieczyszczonej wody. Inwestując w jakość wody, dbamy o zdrowie i bezpieczeństwo wszystkich użytkowników studni. Co więcej, regularne kontrole przyczyniają się do utrzymania dobrej jakości wody na dłuższy czas.


